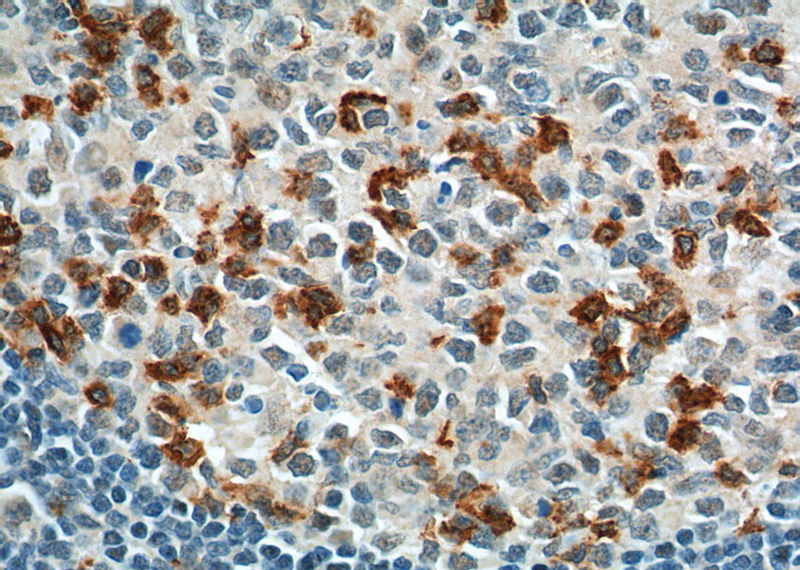
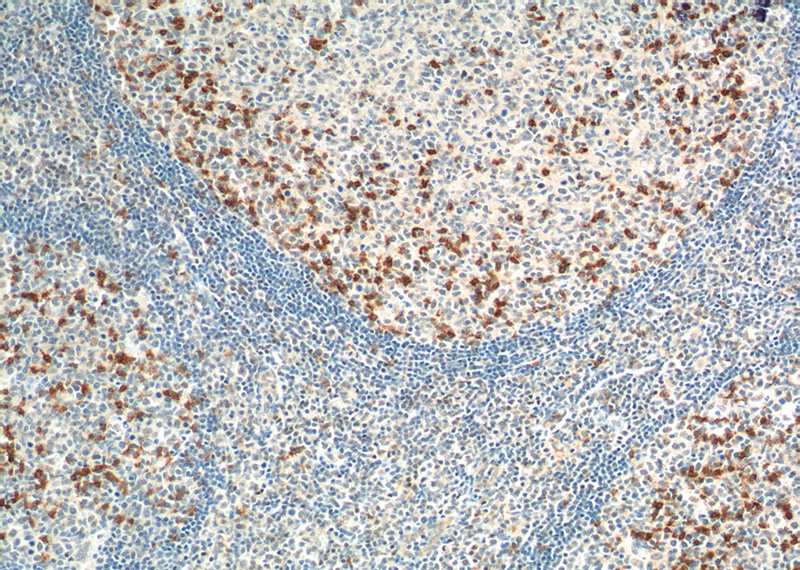

-
Product Name
PD-1/CD279 antibody
- Documents
-
Description
PD-1/CD279 Rabbit Polyclonal antibody. Positive WB detected in HEK-293 cells, K-562 cells, mouse spleen tissue. Positive IHC detected in human tonsillitis tissue, human lymphoma tissue, human ovary tumor tissue. Positive FC detected in HeLa cells. Observed molecular weight by Western-blot: 47 kDa
-
Tested applications
ELISA, WB, FC, IHC
-
Species reactivity
Human, Mouse; other species not tested.
-
Alternative names
CD279 antibody; hPD 1 antibody; hPD l antibody; PD 1 antibody; PD1 antibody; PD-1 antibody; PDCD1 antibody; programmed cell death 1 antibody; Protein PD 1 antibody; SLEB2 antibody
-
Isotype
Rabbit IgG
-
Preparation
This antibody was obtained by immunization of PD-1/CD279 recombinant protein (Accession Number: NM_005018). Purification method: Antigen affinity purified.
-
Clonality
Polyclonal
-
Formulation
PBS with 0.02% sodium azide and 50% glycerol pH 7.3.
-
Storage instructions
Store at -20℃. DO NOT ALIQUOT
-
Applications
Recommended Dilution:
WB: 1:500-1:5000
IHC: 1:20-1:200
-
Validations

HEK-293 cells were subjected to SDS PAGE followed by western blot with Catalog No:113761(PD-1 antibody) at dilution of 1:500
Immunohistochemistry of paraffin-embedded human tonsillitis tissue slide using Catalog No:113761(PD-1/CD279 Antibody) at dilution of 1:200 (under 40x lens). heat mediated antigen retrieved with Tris-EDTA buffer(pH9).
Immunohistochemistry of paraffin-embedded human tonsillitis tissue slide using Catalog No:113761(PD-1/CD279 Antibody) at dilution of 1:200 (under 10x lens). heat mediated antigen retrieved with Tris-EDTA buffer(pH9).

1X10^6 HeLa cells were stained with 0.2ug PD-1/CD279 antibody (Catalog No:113761, red) and control antibody (blue). Fixed with 90% MeOH blocked with 3% BSA (30 min). Alexa Fluor 488-congugated AffiniPure Goat Anti-Rabbit IgG(H+L) with dilution 1:1000.
-
Background
Programmed cell death 1 (PD-1, also known as CD279) is an immunoinhibitory receptor that belongs to the CD28/CTLA-4 subfamily of the Ig superfamily. It is a 288 amino acid (aa) type I transmembrane protein composed of one Ig superfamily domain, a stalk, a transmembrane domain, and an intracellular domain containing an immunoreceptor tyrosine-based inhibitory motif (ITIM) as well as an immunoreceptor tyrosine-based switch motif (ITSM) (PMID: 18173375). PD-1 is expressed during thymic development and is induced in a variety of hematopoietic cells in the periphery by antigen receptor signaling and cytokines (PMID: 20636820). Engagement of PD-1 by its ligands PD-L1 or PD-L2 transduces a signal that inhibits T-cell proliferation, cytokine production, and cytolytic function (PMID: 19426218). It is critical for the regulation of T cell function during immunity and tolerance. Blockade of PD-1 can overcome immune resistance and also has been shown to have antitumor activity (PMID: 22658127; 23169436). It has been reported that PD-1 is heavily glycosylated and migrates with an apparent molecular mass of 47-55 kDa on SDS-PAGE , which is larger than its predicted mass of 32 kDa (PMID: 8671665; 17640856; 17003438). Read more about this antibody on the blog: PD-1 blockade: Priming the Immune System to Combat Cancer
-
References
- Jiang L, Zhao Z, Jiang S. Immunological markers predict the prognosis of patients with squamous non-small cell lung cancer. Immunologic research. 62(3):316-24. 2015.
Related Products / Services
Please note: All products are "FOR RESEARCH USE ONLY AND ARE NOT INTENDED FOR DIAGNOSTIC OR THERAPEUTIC USE"
